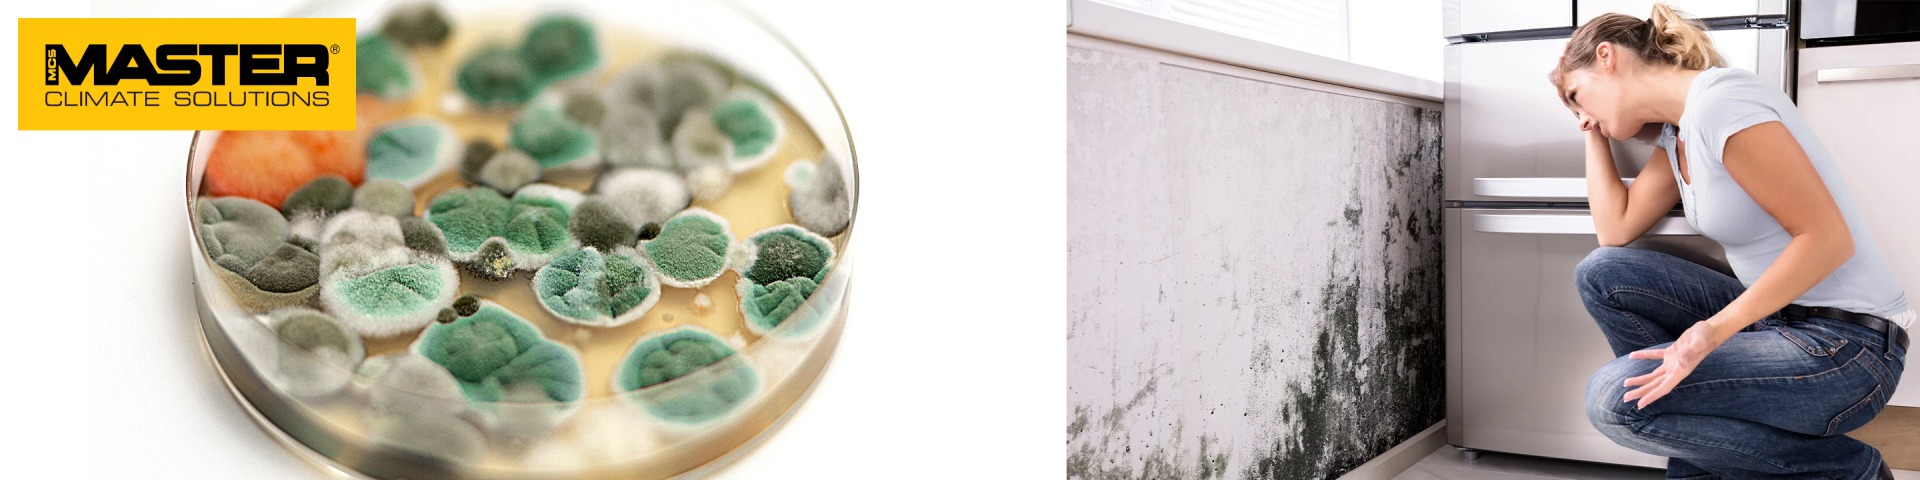
Párátlanító használata penészedés ellen

A penész nedves környezetben fejlődik, és spórákon keresztül terjed. A rossz szigeteléssel vagy szellőzéssel rendelkező régebbi épületek különösen ki vannak téve a nedvességproblémáknak. Megelőzheti a penészedést, ha azonnal kezeli a nedvesség és a víz által okozott károkat. Tartsa a belső páratartalmat 70% alatt, és biztosítson jó szellőzést. Figyeljen az olyan jelekre, mint a dohos szag és a szemmel látható kezdeti penészképződés.
Mi az a penész?
A penészgombák mindenütt jelen vannak. A penész telepekben nő, és az emberi, illetve állati szervezetre káros mikotoxinokat bocsátanak ki. Ezek a mikotoxinok megtalálhatók a padlón, a porban, a fa- és cellulóz alapú anyagokon, valamint a nedves gipszkartonon.
A penész úgy terjed, hogy spórák millióit juttatja a levegőbe, ami azt jelenti, hogy a spórák az épületek minden szegletében megtalálhatók. Amikor a növekedéshez megfelelő feltételek állnak rendelkezésre, a spórák megtelepednek a nedves felületeken, csírázni kezdenek, és új micéliumot képeznek. A micélium apró töredékei a levegőben is felszállhatnak, lehetővé téve új kolóniák létrejöttét.
A legtöbb penészspóra mérete körülbelül 2–10 µm (0,002–0,010 mm), ami azt jelenti, hogy a légáram könnyen hordozza őket, és bejuthatnak az emberi légzőrendszerbe.

A penész elsősorban nedves szerves anyagokon, például tapétán, fán és gipszkartonon nő. Az épületekben csak akkor alakul ki penészgomba, ha az anyagok kellően nedvesek, és a nedvességtartalom megegyezik a levegővel egyensúlyban lévő 75-80%-os relatív páratartalom mellett. Más szóval, ha a relatív páratartalom 70% alatt van, nem valószínű, hogy penészgomba alakul ki. Azonban helyi nedves körülmények, például nedvesség behatolása a falakba, továbbra is előfordulhat.
A penész fontos szerepet játszik a természet tápanyag-ciklusában, és az élelmiszer- és gyógyszeriparban is használják. A penész azonban kényelmetlenséget és káros egészségügyi hatásokat is okozhat mind beltéri, mind kültéri környezetben.
Hogyan hat a penész az emberi egészségre?
A penész allergéneket (olyan anyagokat, amelyek allergiás reakciókat válthatnak ki) és irritáló anyagokat termel. A penész vagy a penészgombák spóráinak belélegzése vagy megérintése allergiás reakciókat válthat ki az erre érzékeny egyéneknél.
A penészgomba elleni allergiás reakciók gyakoriak, és hatásuk lehet azonnali vagy akár késleltetett is. A penészre allergiás asztmás betegeknél rohamokat válthat ki.
Irritáció
Az irritáció a nedvességnek való kitettséggel és a penészgomba növekedésével kapcsolatos leggyakoribb egészségügyi hatás. A tünetek közé tartozhat a szem, az orr és a felső légutak irritációja, fejfájás, fáradtság, köhögés és bőrkiütések. A szénanáthás és asztmás emberek különösen érzékenyek. Ezenkívül a légúti irritáció növelheti a légúti fertőzések kockázatát.
Azoknál a gyerekeknél, akik magas páratartalmú otthonban nőnek fel, fokozott az asztma kialakulásának kockázata. Szélsőséges esetekben, ahol kiterjedt a penészesedés és a levegőben magas a mikotoxinkoncentráció, súlyos toxikus reakciókat figyeltek meg.
Allergia
Antigén fehérjéket (allergéneket) tartalmazó penészgombákkal való ismételt érintkezés esetén allergiás reakciók léphetnek fel. Ritka, hogy az egyénekben csak a nedves épületekben való tartózkodástól alakul ki penészgomba-allergia, de nagyobb a kockázata azoknak, akik már hajlamosak az allergiára, például szénanáthára vagy asztmára, vagy akiknek légutak érzékenyek. A penészgombákra allergiában szenvedők súlyosbodhatnak a tünetek.
A beltéri klíma szabályozásának fontossága
A nedves beltéri környezet elősegítheti a penész és a poratkák növekedését. Mivel a nyugati világban az emberek idejük 80-90%-át zárt térben töltik, a jó beltéri klíma elengedhetetlen az egészséghez és a jó közérzethez, különösen a nedvesség, a penész és az egészség szempontjából.
A relatív páratartalom (RH) a levegőben lévő vízgőznyomást jelenti, a telített gőznyomás százalékában kifejezve ugyanazon a hőmérsékleten. Az RH a levegőben lévő vízgőz mennyiségét és a levegő hőmérsékletét egyaránt tükrözi. Például az relatív páratartalom növekszik, ha a levegőtömeg hőmérséklete csökken, de a víz nem távozik. Ha a levegő megfelelően lehűl, a vízgőz egy része folyékony vízzé kondenzálódik. A legmagasabb hőmérsékletet, amelyen a páralecsapódás előfordul, "harmatpontnak" nevezik.
Milyen jelei vannak a penészesedésnek egy épületben?
Ha azt gyanítja, hogy a fent említettekhez hasonló egészségügyi tüneteket egy nedves épület okozza, ahol penészgombák vannak, akkor szakemberrel kell felmérni az ingatlant.
A hosszan tartó, több hétig vagy tovább tartó nedvesség jellemzően penészesedést és spórák beltéri levegőbe kerülését eredményezi, ami növeli a kitettség kockázatát. A rövid távú nedvességproblémák, amelyek néhány napon belül kiszáradnak, valószínűleg nem okoznak penészesedést.
Figyeljen a fekete foltokra, dohos szagra
A penész gyakran fekete foltként jelenik meg, de sok esetben nehéz észrevenni, mert a tapéta mögött vagy a falüregekben nőhet. A rosszul szigetelt szellőzőrendszerekben vagy az eltömődött lefolyókkal rendelkező klímaberendezésekben is penész alakulhat ki.
Mivel nehéz észrevenni, ezért kiemelten fontos odafigyelni a nem odaillő szagokra, ilyen például a jól ismert dohos szag is. Az erős dohos szag jól jelzi a nedvességproblémákat. Ezt a jelenséget az illékony szerves vegyületeket (VOC) kicsobátó penészgombák okozzák, aminek a következménye a dohos vagy nedves szag.

Miért fordul elő nedvesség az otthonokban?
Az otthoni nedvességproblémáknak számos oka lehet:
- Felszivárgó nedvesség. A talajból származó víz beszivárog az épületbe. Ez gyakori a régebbi épületekben, de akár újabb épületek építési hibái is okozhatják. A hozzájáruló tényezők közé tartozik az eltömődött lefolyók, az alapok nem megfelelő tömítése és a tető elégtelen vagy eltömődött vízelvezetése.
- Magas beltéri páratartalom az olyan tevékenységek miatt, mint a fürdés, főzés, takarítás, mosás, valamint az emberi és állati légzés. Ha több nedvességet adnak a beltéri levegőhöz, mint amennyit a szellőzéssel eltávolítanak, a pára lecsapódhat a falfelületeken vagy az ablakokon.
- Nem megfelelő természetes vagy mechanikus szellőzés.
- Rossz szigetelés, hőhidak.
- Víz behatolása árvíz vagy eső miatt.
- Épületszerkezetekben az építőanyagok nem megfelelő száradása vagy építési hibák miatti vízkárok, amelyek új építésű ingatlanokban is előfordulhatnak.
- Látható vagy rejtett csőszivárgás, amelyet korrózió, szakadás vagy szivárgó csatlakozások okoznak. A nagyobb árvizek mellett a kis, fel nem fedezett szivárgások a legkárosabbak, mivel idővel nedvességproblémákat okozhatnak, elősegítve a penészgombák növekedését, valamint károsíthatják az anyagokat és az épületszerkezeteket.

Hogyan előzheti meg a penész kialakulását otthonában?
Az egészségügyi kockázatok minimalizálása érdekében kulcsfontosságú a nedvesség okának gyors azonosítása és kezelése, a penészgombák hatékony eltávolítása, valamint az érintett területek gyors kiszáradása az újbóli előfordulás megelőzése érdekében. Bizonyos esetekben ezt saját maga is meg tudja tenni, de gyakran szakmai segítségre van szükség a munka megfelelő elvégzéséhez. Bármilyen vízkárt meg kell javítani, mert nem csak penészedést okoz, hanem az épület szerkezetét és szigetelési tulajdonságait is gyengítheti.
Az építőipari szakemberek elvégezhetik az ingatlan műszaki vizsgálatát, a penészgomba növekedésére összpontosítva. A nedvesség által károsodott területeken a penészedés azonosítására falakról, tapétákról, faanyagokról és egyéb anyagokról lehet mintákat venni.
Alacsonyabb páratartalom
A páratartalom csökkentése elengedhetetlen, akár a szellőztetés fokozásával, akár a párátlanítással. A fűtés önmagában nem elegendő megoldás. A meleg levegő több nedvességet képes megtartani, mint a hideg levegő, ami alacsonyabb relatív páratartalomhoz vezet. Ha azonban meleg levegő érintkezik hideg felületekkel, a pára nedvességként lecsapódhat. Ez gyakran látható az ablakok körül, rosszul szigetelt helyeken (hőhidak), vagy nem megfelelően fűtött helyiségekben. A hálószoba hőmérsékletének alacsonyan tartása elősegítheti a penészgombák növekedését ezekben a helyiségekben, ezért a hálószobákat napközben jól szellőztetni és fűteni kell.
Ha egy nedves fal meleg marad a napfény vagy a kazánház közelsége miatt, a penészgombák gyorsan fejlődhetnek, mivel a magasabb hőmérséklet elősegíti a növekedést.
Ideális esetben a belső páratartalmat 45-50% között, de mindenképpen 70% alatt kell tartani. Ez stabil hőmérsékleten, szellőztetéssel és szükség esetén páramentesítéssel érhető el.
A különféle nedvességmérők mind a relatív páratartalom, mind az anyagnedvesség szintjét mérni tudják. (https://eurokomax.hu/paratlanitok-paramentesitok/hfm200)
Ha többet szeretne megtudni arról, hogy hogyan tudunk segíteni a penészesedés megelőzésben vagy kezelésében, kérjük lépjen kapcsolatba velünk még ma. (ugyfelszolgalat@eurokomax.hu)
Forrás: dantherm.com